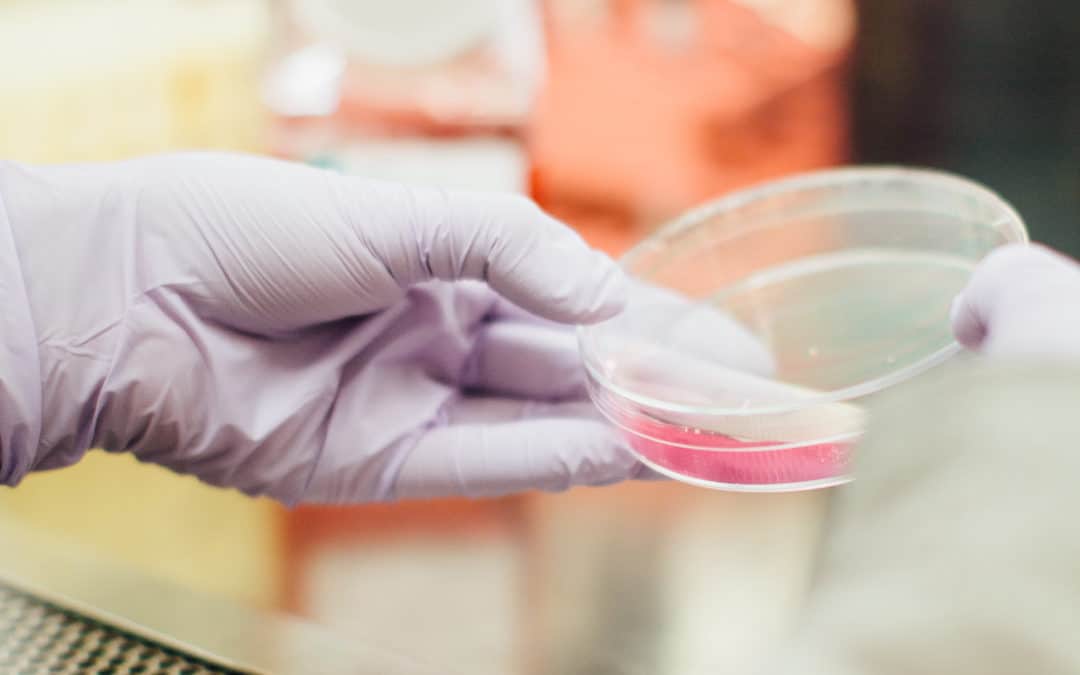
Good Practices to Tackle Antimicrobial Resistance

by European Public Health Alliance | May 31, 2022 | Reports
By Kirsty Douglas – Policy Assistant for Global Public Health Antimicrobial resistance (AMR) is an ongoing public health crisis, with a recent report associating bacterial AMR with 4.95 deaths per year worldwide, including 1.27 million attributable deaths. This is a...

by European Public Health Alliance | Mar 8, 2022 | Reports
Antimicrobial resistance (AMR) continues to be a major global health concern, with the latest statistics showing nearly 200 000 deaths were associated with AMR in Europe in 2019 alone. It is imperative that efforts to tackle this issue are realised at every level of...

by European Public Health Alliance | Jan 28, 2022 | Position & Policy Papers, Reports
Achieving deep reductions in farm antibiotics use will require widespread changes in animal husbandry practices towards higher animal welfare, argues a new paper written for EPHA. On 28 January 2022, ambitious rules restricting the use of veterinary antimicrobials...

by European Public Health Alliance | Dec 21, 2021 | Reports
EPHA’s access to medicines, A2MDialogues series started in the second half of 2020 with five episodes of an-hour long, live, online conversations with key decision-makers shaping medicines’ policies in Europe. The series continued in 2021 with four additional episodes...

by European Public Health Alliance | Dec 17, 2021 | Opinion, Reports
On Tuesday 7 December 2021, the European Public Health Alliance (EPHA) hosted an online discussion on working in partnership with civil society in the context of the COVID-19 pandemic in the frame of the EPHA 2021 AnnualGeneral Assembly. Following the keynote speech...

by European Public Health Alliance | Dec 13, 2021 | Opinion, Reports
The determinants of health shape the conditions in which we are born, grow, live, work, and age, and explain the unfair, systematic, and avoidable differences in health between groups of people: health inequalities. The social determinants of health include income...